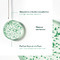
Furterer Forticea Shampooing Fortifiant 200ml

Propriétés
Le shampooing fortifiant Furterer Forticea convient à tous les types de cheveux. Il associe le guarana, puissant énergisant naturel, aux vitamines B5 et B3, ou niacinamide, et aux précieux pouvoirs d'un cocktail d'huiles essentielles stimulantes, réunies dans de petits globules. L'ensemble est idéal pour renforcer la vigueur des cheveux. L'apport en vitamines et en éléments énergétiques est intensifié dès la racine. Le résultat est une fibre capillaire plus forte, plus résistante et plus belle. Les cheveux sont plus forts, plus sains et débordent d'énergie chaque jour. Aériens au toucher et faciles à coiffer, les cheveux gardent une forme parfaite.
- Nettoyage en douceur
- Renforce les cheveux
- Facilite le coiffage
- Parfum vivifiant
Indication
Shampooing fortifiant et revitalisant pour tous les types de cheveux.
Utilisation
- Appliquer sur le cuir chevelu mouillé et masser délicatement par des mouvements circulaires.
- Laisser agir 1 à 3 minutes.
- Rincer.
Ingrédients
aqua*. lauryl glucoside*. sodium cocoyl alaninate*. coco-betaine. agar*. algin*. benzoic acid. caffeine. calcium gluconate. cellulose*. cellulose gum*. chromium hydroxide green (ci 77289). chromium oxide greens (ci 77288). citric acid*. citrus aurantium dulcis (orange) oil (citrus aurantium dulcis oil)*. fragrance (parfum). gluconolactone*. glycerin*. green 3 (ci 42053). hydroxypropyl guar hydroxypropyltrimonium chloride. lavandula angustifolia (lavender) oil (lavandula angustifolia oil)*. lavandula hybrida oil*. limonene*. linalool*. maltodextrin*. methyl glucose dioleate. niacinamide. panthenol. pantolactone. paullinia cupana seed extract*. propanediol. rosmarinus officinalis (rosemary) leaf oil (rosmarinus officinalis leaf oil)*. sodium benzoate. talc. tocopherol. tocopheryl acetate. yellow 5 (ci 19140)
Propriétés
| Propriétés | Sans silicone |
|---|---|
| Type de cheveux | Cheveux secs | Hydratant, Cheveux fins | Volume, Cheveux abîmés | Fortifiant, Cheveux gras | Purifiant, Cheveux colorés | Cheveux blondes, Cheveux normals |
| Type de soins capillaires | Shampooing |
| Code de l'article | 4517058 |
Furterer Forticea Shampooing Fortifiant 200ml
Shampooing fortifiant et revitalisant pour tous les types de cheveux.
Le prix le plus bas des 30 derniers jours € 16,65
Votre avantage par rapport au prix de lancement € 22,50 (-20%)
Temporairement indisponible
Ce produit est temporairement en rupture de stock
Livraison rapide
Expédition sous 1 à 2 jours ouvrés
Livraison rapide
Expédition sous 2 à 3 jours ouvrés
Temporairement indisponible
Ce produit est temporairement en rupture de stock
Hors d'affaire
Ce produit n'est plus commercial
Le produit n’est pas disponible à ce moment